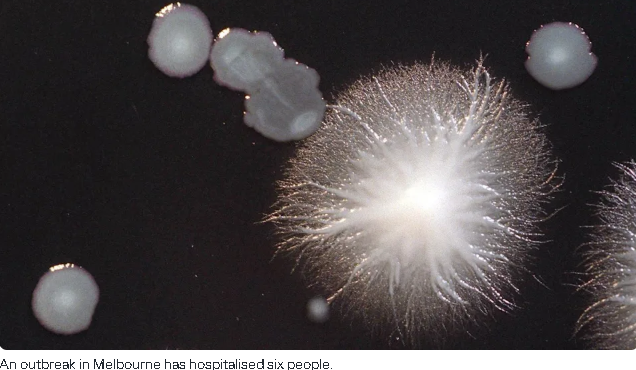

收藏
收藏卫生部连发警报,墨尔本出现致命细菌感染,多人住院!紧急追踪病源
这事值得大家关注。
墨尔本北边一个区突然爆出一种“比较危险的细菌感染”,已经让卫生部紧急进入调查状态。
目前确认是在Craigieburn以及周边区域,已经有6人确诊感染“军团菌病”,而且全部都在3月初出现症状,

这些病例,症状严重到需要住院治疗,所以政府马上启动了公共卫生应对。
现在的重点就是找源头。
卫生部判断,这波感染大概率是从2月底开始的,正在重点排查像冷却塔、供水系统这些地方,
因为这种细菌很容易藏在这些水系统里,通过水雾传播出来。
政府也已经提醒在Craigieburn、Mickleham、Greenvale和Roxburgh Park这几个区域活动过的人,
如果出现类似流感的症状,比如发烧、发冷、肌肉酸痛、一直咳嗽,一定要尽快去看医生。

“军团菌病”
是由一种叫军团菌的细菌引起的。这种细菌其实在自然水源(河流、湖泊)和一些人工设备(比如温泉、冷却系统)里都可能存在。
它的传播方式,不是人与人之间传染,而是通过吸入被污染的水雾感染。
大多数人就算接触到也不一定会生病,但风险比较高的人群包括:年纪大的人、吸烟的人,还有免疫力比较弱或者本身有基础疾病的人。
医生现在也被特别提醒了,如果遇到严重或者不太典型的肺炎病例,尤其是最近去过这些区域的,要优先考虑是不是这个病。
因为这个病如果能早点发现,用抗生素是可以治的,但拖久了可能会发展成严重肺炎,甚至影响肾功能。

卫生部也强调,一旦医生怀疑是这个病例,必须立刻上报,这样才能尽快控制住这波感染,并找到真正的源头。
整体来看,这次事件还在可控范围内,大家不用恐慌,但也别掉以轻心。
对在墨尔本生活的华人来说,最近如果正好在这些区域活动过,就多留意一下身体变化。该上班上班、该生活生活,但一旦有不对劲,及时就医比什么都重要。
本文为转载发布,仅代表原作者或原平台态度,不代表我方观点。澳洲印象仅提供信息发布平台,文章或有适当删改。对转载有异议和删稿要求的原著方,可联络 [email protected]

































你需要登录后才能评论 登录